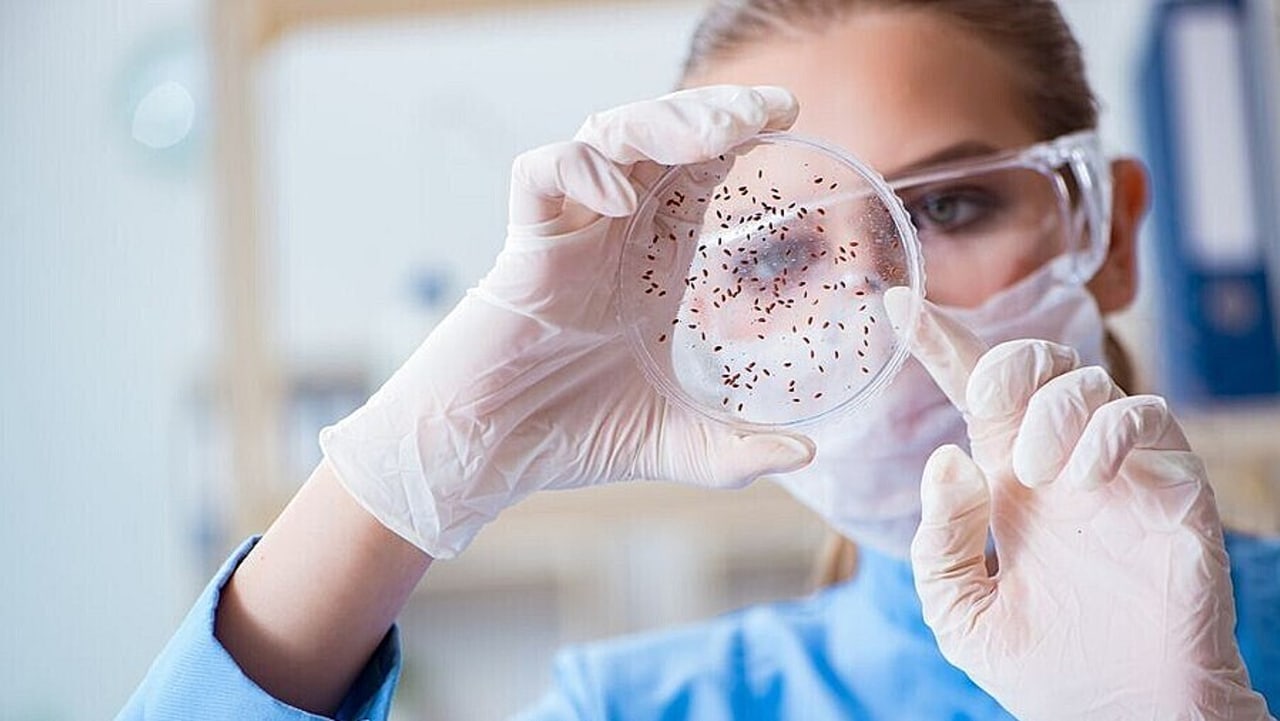
26% des CHU ont pris des participations dans des start-up. (Ingram/BSIP)

15h12
Article
Stéphanie Rist promet une feuille de route sur l'aval pour désengorger les urgences
Par Géraldine Tribault — à Lille
2 décembre 2024 à 15h53
Les CHU veulent rappeler leur rôle de créateur de valeur sur leur territoire. En introduction de la 3e édition du CHU Healthtech connexion day organisé ce 2 décembre…
La couverture complète des enjeux des territoires de santé, du sanitaire au médico-social.
Une édition synthétique envoyée chaque matin par email et un site mis à jour en temps réel.
Des contenus professionnalisants sur plus de 30 thématiques
Un accompagnement des managers et des gestionnaires dans leurs prises de décisions depuis plus de 20 ans.